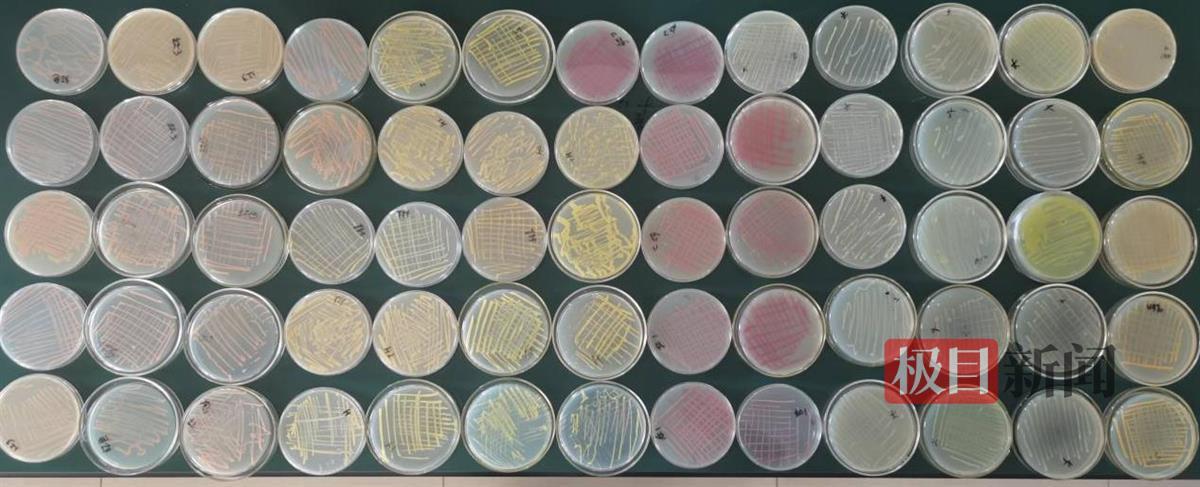
6be53e8dabdcf4978a9ee1393b6bf14f_pub_CB20231120203128787081.png
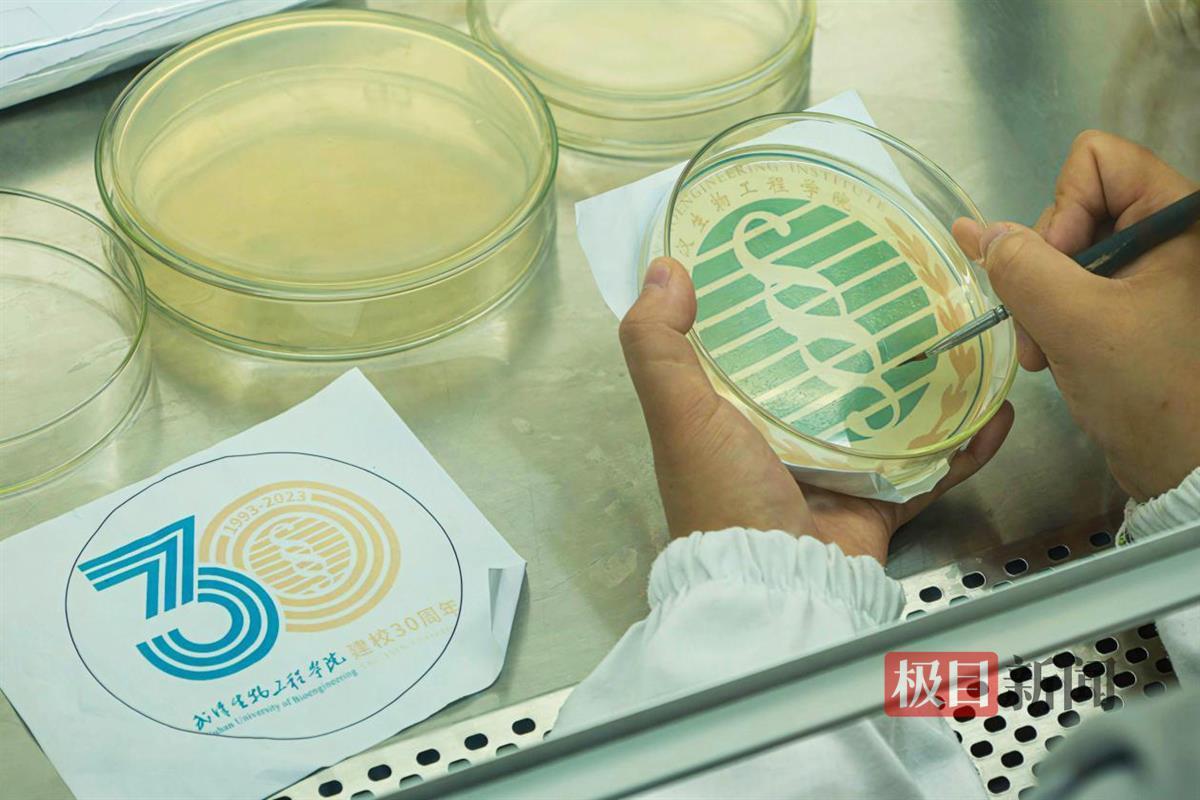

极目新闻记者 柯称
通讯员 李春艳
摄影 吴云松
以微生物为墨,培养皿当画布,用“盲画”的形式绘制出校门主景观、教学楼、校园长城雄关、校庆标识等,待繁殖形成菌苔即可成画……在武汉生物工程学院30周年校庆日到来之际,该校生命科学与技术学院2024届准毕业生曹盛林和同学们为学校送上了一份高技术含量的生日礼物——“细菌画”。
 曹盛林(左二)和团队成员携“细菌画”与校门合影
曹盛林(左二)和团队成员携“细菌画”与校门合影
 曹盛林团队原创武生院30周年校庆主题“细菌画”
曹盛林团队原创武生院30周年校庆主题“细菌画”
曹盛林介绍,绘制“武生院”字样和学校校徽、30周年校庆标识的主要是粘质沙雷氏菌,藤黄微球菌细菌,肉色细菌,表达绿色荧光蛋白的大肠杆菌;学校校门主景观、一号教学楼和雄关等图案则是由土黄细菌、肉色细菌、藤黄微球菌和粘质沙雷氏菌培养得来。值得一提的是,这些“细菌画”呈现的色彩均是纯天然的,没有任何成品颜料涂色参与。细菌也并非人们印象中的有害物质,而是学生利用微生物实验课知识,采用从土壤中分离未知菌的方法,经过选样、筛选、过滤得到的,没有毒性。
课堂学习激发了创作灵感
刚入大学时,曹盛林就加入了学校微生物及应用协会。在老师和学长学姐的熏陶下,开始接触微生物实验,而真正踏足细菌画是在大三时,曹盛林在指导老师范萌的推荐下,参加了由湖北省科学技术协会、华中农业大学主办,国家农业生命科学技术科普基地承办的湖北第一届微生物培养皿艺术设计大赛。
初出茅庐,因技术不够成熟而无缘大奖。但曹盛林没有气馁,而是找到范萌,查阅文献,重新理解细菌绘画的原理。“微生物的培养繁殖就是一幅艺术作品的创作过程。文科生用铅笔画画,我们可以拿细菌画画。”经过多番推导,曹盛林的思路逐渐清晰起来:用接种环在培养皿上按预先设计好的图案描绘线条,然后放入恒温培养箱培养一至两天后,这些微小的生命便能长出丰富多彩的图案……
曹盛林团队在作画过程中用到的有色菌种(受访者供图)
曹盛林团队在作画过程中用到的有色菌种(受访者供图)
用什么绘画?如何从自然环境中找到合适的菌种?怎么让菌种顺利“长”成一幅漂亮的画?最大的难点是对“颜料”的提纯。因为一旦混入了其他细菌或者纯化程度不足,就无法实现预想的色彩。在范萌的指导下,曹盛林一下课就跑去收集有色菌。校园里的肥沃土壤、空气、水池以及皮肤表面……最终通过无菌操作,顺利筛选得到了粘质沙雷氏菌、土黄色细菌、肉色细菌等6个显色鲜艳的菌种。
 曹盛林(左)和搭档尚小琴(右)在学校地标景观雄关下与作品合影
曹盛林(左)和搭档尚小琴(右)在学校地标景观雄关下与作品合影
 团队成员董冰在学校一号教学楼前与作品合影
团队成员董冰在学校一号教学楼前与作品合影
解决了菌种问题,第二个考验也随之而来。不同菌种需要的培养基和培养环境不尽相同,要把不同种类、不同颜色的菌种“合成”在一个培养基上,难度也很大。选择什么接种工具?用多大的培养皿?温度多少、培养多长时间?曹盛林和团队成员试了几十种搭配组合。“每幅画大概要尝试十几个皿,我们才确定哪几种微生物在同一个培养基上,温度设几度,培养几个小时是最好的搭配,才会呈现最好的画面。”
以赛促学练就“灵魂画手”
2023年7月,曹盛林报名了湖北第二届微生物培养皿艺术设计大赛,这一次他将积攒了近两年的绘画经验和盘托出。为了交出高质量的参赛作品,曹盛林拉着搭档们反复打磨。
 团队参加湖北第二届微生物培养皿艺术设计大赛,“一带一路”作品(受访者供图)
团队参加湖北第二届微生物培养皿艺术设计大赛,“一带一路”作品(受访者供图)
“细菌作画既要熟悉微生物的特性,也需要较高的艺术素养。”曹盛林经常鼓励搭档打开“脑洞”。然而生活中常见的微生物菌种一般都是乳白色的,稀释后的菌液近乎透明,绘制过程中,画手只能进行“盲画”,线条更难控制。考虑到绘制难度,团队经过测试对比后,决定用直径为15厘米和9厘米的培养皿充当画布。可即便如此,最终培养出来的画面还是不够理想。
团队成员尚小琴(左)和梁晓阳(右)正在“盲画”
团队成员尚小琴(左)和梁晓阳(右)正在“盲画”
“在纸上画是黑白分明的,但是用细菌画就会出现不可控性。”团队成员梁晓阳说。如何挑选合适的菌种,并让微生物朝着设定的方向生长?为了解决这个问题,曹盛林和搭档们只能不断练习绘制手法,起初使用的接种环换成了灭菌后的勾线笔,绘制的菌液则直接用提取的菌种原液,以期勾勒出流畅的线条和整洁的画面。终于,日复一日的训练奏效了,团队顺利完成了作品绘制。
倾注感恩打造“理科浪漫”
有了专业性赛事的经验,曹盛林和团队成员们也越来越自信。随着学校30周年校庆日来临,曹盛林提前一个月召集团队成员,策划用微生物绘制校园地标景观,以此表达对学校的美好祝愿和感激之情。“细菌画画是一个‘耐心造就奇迹’的过程。每一幅画都要近一个月的创作期,过程十分烦琐。”尚小琴说,“但这是对我们的微生物知识学习成效的检验,更是我们对学校浓烈情感的结晶,再麻烦都值得!”
 团队成员梁晓阳(左)与惠笑闯(右)在校门口与作品合影
团队成员梁晓阳(左)与惠笑闯(右)在校门口与作品合影
“微生物作画实验不仅有助于推动微生物科学知识普及,还有利于提高大学生对美的认知和创作能力,是专业教学与美育实践的有益探索。”该校生命科学与技术学院院长助理孙文超说,通过这一跨学科的尝试,可以培养学生乐学、善学、勤学、博学理念和创新创作能力,丰富同学们的课余生活,激发青年大学生投身科研事业的意愿。
“在离开武生院之前,为母校献上一份独属于生科院理科生的礼物,也留下独属于我的武生院记忆。”毕业实习之际正逢母校30周岁生日,曹盛林内心充满对母校培育的感激之情。
